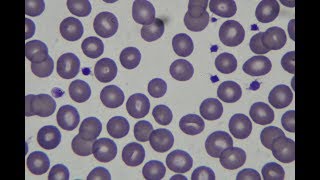

Helping People Everyday To Manage Their Health
From counseling, doctor consults, diagnostic tests at the best labs, prescriptions, and medicines, to preventive care & rehab - we provide the full spectrum of care.
Caring Doctors
Personalized care by a team of qualified & trained experts
Advanced Labs
Best in class, certified & accredited lab partners
Pharmacy services
Medicines at the best prices are delivered at your doorstep
Rehab Services
Experts and counselors team up to support you till you need
Shared 4 weeks ago
95 views
Shared 4 months ago
67 views
Shared 1 year ago
135 views
Shared 1 year ago
56 views
Shared 1 year ago
181 views
Shared 1 year ago
113 views
Shared 1 year ago
238 views
Shared 2 years ago
158 views
Shared 2 years ago
64 views
Shared 2 years ago
6.6K views
Shared 2 years ago
432 views
Shared 3 years ago
2.5K views
Shared 3 years ago
726 views
Shared 3 years ago
790 views
Shared 3 years ago
622 views
Shared 3 years ago
3.7K views
Shared 5 years ago
283 views
Shared 5 years ago
649 views
Shared 5 years ago
917 views
Shared 5 years ago
1.4K views
Shared 5 years ago
48 views
Shared 5 years ago
621 views
Shared 5 years ago
200 views
Shared 5 years ago
133 views
Shared 7 years ago
185 views
Shared 7 years ago
472 views
Shared 8 years ago
21K views
Shared 8 years ago
170K views
Shared 9 years ago
664 views
Shared 9 years ago
654 views
Shared 10 years ago
347K views
Shared 10 years ago
376 views
Shared 10 years ago
2.8K views